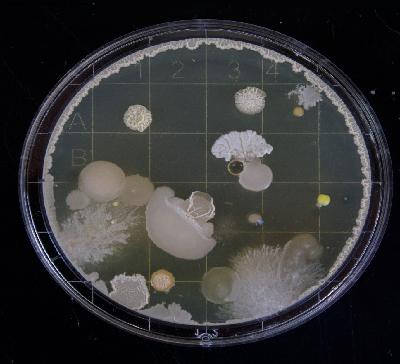
Episode 6: Bugs, Drugs & Antibiotic Stewardship in Vermont

Discover
Green Mountain Medicine
Green Mountain Medicine
Author: ACPVermont
Subscribed: 10Played: 72Subscribe
Share
© Copyright 2019 All rights reserved.
Description
Green Mountain Medicine is an original podcast series for all things internal medicine, sponsored by ACP Vermont. Hosted by University of Vermont medical students Sam Schuetz and Aneesh Singal, this podcast deconstructs the topics that impact the field and characterize the practice of medicine. Episodes are also available on Spotify, Apple Podcast & Google Play Music! DISCLAIMER: Content discussed in our podcast does not necessarily constitute the views of ACP national.
52 Episodes
Reverse
Join your new hosts, Caity and Haley, in saying goodbye to our former hosts, Aneesh and Sam, as they graduate from LCOM and begin their journey as internal medicine interns at Tufts Medical Center and Beth Israel Deaconess Medical Center (respectively). We chat about our story of getting to medical school, and some other fun topics of discussion.
Co-Hosts:
Caity Decara: caitlin.decara@med.uvm.edu
Haley Bayne: haley.bayne@med.uvm.edu
On this episode of GMM, we are joined by Dr. Elly Riser, a hospitalist and assistant professor of medicine at UVMMC. We discuss recent changes in the treatment of opioid use disorder, the landscape of harm reduction and treatment options in Vermont, and the importance of a multifaceted approach to addiction treatment.
We also learned several fantastic clinical pearls about pharmacology and managing acute pain in patients with opioid use disorder.
Co-Hosts:
Aneesh Singal: aneesh.singal@.med.uvm.edu
Sam Schuetz: samantha.schuetz@med.uvm.edu
On this episode of Green Mountain Medicine, join us for a special show hosted by UVM 3rd year medical student, Jeremy Altman. Throughout this episode, Jeremy interviews three medical students about their non-traditional paths to medicine and the interesting things they did before starting medical school.
Eliot Binkerd: Beginning of the show
Lauren Tien: 20 minutes 38 seconds
Taylor Drake: 51 minutes 39 seconds
Special Guest Host: Jeremy Altman: jeremy.altman@med.uvm.edu
Co-Hosts:
Aneesh Singal: aneesh.singal@.med.uvm.edu
Sam Schuetz: samantha.schuetz@med.uvm.edu
Thumbnail: Paul Iwancio/Creative Commons
In this episode of Green Mountain Medicine, we are joined by Dr. Jim Li, an Assistant Professor of Medicine at UVM and a practicing hospitalist to discuss the importance of healthcare informatics, how implementing an electronic medical record helps to bring us together, and where technology might continue to change healthcare in the coming decades.
Co-Hosts:
Aneesh Singal: aneesh.singal@.med.uvm.edu
Sam Schuetz: samantha.schuetz@med.uvm.edu
Thumbnail: Paul Iwancio/Creative Commons
On this episode of GMM, we are joined by Dr. Devika Singh, MD and Zpora Perry, LICSW to discuss modern HIV stigma, the power of advocacy, and building trust with marginalized communities.
More about the history of HIV/AIDs: https://www.hiv.gov/hiv-basics/overview/history/hiv-and-aids-timeline
To make a confidential appointment and learn about your HIV/AIDS care options, call UVM Medical Center's HIV/ AIDS Comprehensive Care Clinic toll-free: 800-358-1144 ext. 4594
In this episode of Green Mountain Medicine, we are joined by Dr. Kevin Qin and Dr. Matt Gervais, two of UVM's internal medicine chiefs to talk about chief year, their careers, and the many wonders of living and working in Vermont.
Co-Hosts:
Sam Schuetz: samantha.schuetz@med.uvm.edu
Aneesh Singal: aneesh.singal@.med.uvm.edu
Thumbnail: Paul Iwancio/Creative Commons
In this episode of Green Mountain Medicine, we are joined by Dr. David Rand, an assistant professor of medicine, oncology hospitalist and palliative care physician at UVM Medical Center. We discuss his path to medicine, the pros and cons of global health experiences for medical trainees, and how to have a successful goals of care conversation.
Guests: Dr. David Rand DO
Co-Hosts:
Aneesh Singal: aneesh.singal@.med.uvm.edu
Sam Schuetz: samantha.schuetz@med.uvm.edu
Thumbnail by Memorial Healthcare
In this episode we are joined by infectious disease physician and Professor of Medicine Dr. Tim Lahey as we discuss vaccine scale up and hesitancy in the United States and how Vermont used its social capital and followed the science to lead the nation in the vaccination effort. We consider vaccine mandates, return to a new normal, and the role of physicians as advocates for public health.
Guests: Dr. Tim Lahey MD MMSc
Co-Hosts:
Aneesh Singal: aneesh.singal@.med.uvm.edu
Sam Schuetz: samantha.schuetz@med.uvm.edu
Thumbnail by Daniel Schludi on Unsplash
Join your new hosts, Sam and Aneesh, in saying goodbye to our pioneering old hosts, Dylan and Matt, as they graduate from LCOM and begin their journey as internal medicine interns at Emory University and Beth Israel Deaconess Medical Center. We chat about favorite rotations, advice for clerkships, life in medicine, and best Vermont memories.
Guests:
Matt Tsai MD: matthew.tsai@med.uvm.edu
Dylan Koundakjian MD: dylan.koundakjian@med.uvm.edu
Co-Hosts:
Aneesh Singal: aneesh.singal@.med.uvm.edu
Sam Schuetz: samantha.schuetz@med.uvm.edu
In this episode, we are joined by Internal Medicine PGY-3s and soon-to-be fellows Dr. Carrie Mahurin and Dr. Jen Bergeron. Together, they review the evidence for or against a broadened therapeutic role of SGLT2 Inhibitors beyond diabetes treatment, in light of new trials suggesting efficacy in heart failure and chronic kidney disease management.
Guests: Dr. Carrie Mahurin, MD, PGY3 at UVMMC, and Dr. Jen Bergeron, MD, PGY3 at UVMMC
Thumbnail by Kate Hliznitsova on Unsplash
In this episode, we are joined by guest co-host Sienna Searles (MS4), Dr. Polly Parsons, and Dr. Bridget Marroquin in a conversation about the experience of women in medicine. We discuss gender disparities and ways we can work to close the gap as a field, as allies, and as advocates.
Expert Guests:
(1) Dr. Polly Parsons, LCOM L. Amidon Chair and Professor of Medicine & UVMMC Medicine Health Care Service Leader
(2) Dr. Bridget Marroquin, LCOM Associate Professor of Anesthesiology
Guest Co-Host: Sienna Searles (MS4)
Thumbnail by Sammie Vasquez on Unsplash
In this episode, we speak with Dr. Garth Garrison on the utility of pulmonary prehabilitation in reducing post-operative complications and morbidity in patients scheduled for elective surgery, especially during an era when shelter-in-place orders and social distancing are the norm. We also discuss potential ways prehabilitation can be applied outside of the pre-operative setting.
Expert Guest: Dr Garth Garrison MD
Co-Hosts:
-Dylan Koundakjian (dylan.koundakjian@med.uvm.edu)
-Matt Tsai (matthew.tsai@med.uvm.edu)
Thumbnail by Jeremy Lapak on Unsplash
In this episode, we speak with Vermont Health Commissioner and former ACP VT Governor Dr. Mark Levine, on his experience as a physician leader in government during the COVID19 pandemic. We discuss his career path into public health, the role of physicians in government and the pandemic as we know it - from lessons learned to challenges ahead.
Guest: Dr. Mark Levine MD
Thumbnail by Martin Sanchez on Unsplash
Our last bonus segment highlighted some of our amazing medical student peers in Vermont. Now, we are shining the spotlight on the equally incredible faculty members at the Larner College of Medicine. They share their thoughts on how COVID19 has impacted them in their professional and personal lives.
Guest Faculty (in order of appearance): Dr. Lewis First MD MS, Dr. Emily Greenberger MD, Dr. Meredith Collins MD, Dr. Andy Hale MD, Dr. Jen Gilwee MD, Dr. Jeremiah Dickerson MD, Dr. Elise Everett MD MSC, Dr. Matt Gilbert DO
Background Music by Shane Ivers: Bright Ideas, Fresh Lift, Precious Memories - https://www.silvermansound.com
Thumbnail by Emil Widlund on Unsplash
In this bonus addition to our podcast Episode 8: Medical Education in the Time of COVID19, several of our awesome Larner College of Medicine medical student classmates share their stories and take on how the pandemic has impacted them at different levels of their medical training.
Guests: Sienna Searles (M3), Tyler Prince (M3), Megan Garrido (M3), Alim Esemenli (M2), Diana Salama (M1), Rio Beardsley (M3), Jhaimy Fernandez (M3) and Vinh Le (M1)
Background Music: Tomorrow's Times by Shane Ivers - https://www.silvermansound.com
Thumbnail by ConvertKit on Unsplash
In this episode, we interview Larner College of Medicine Dean Richard Page for his take on how COVID19 has impacted the current and future landscape of medical education. We discuss recent national and local changes to the training of future physicians, the exciting potential of telemedicine, and the challenges this unprecedented time poses to medical students.
Keep an eye out for an upcoming bonus episode featuring Larner College of Medicine students sharing their stories and perspectives on MedEd.
Guest: Dr. Richard Page
Thumbnail by Nathan Dumlao on Unsplash
In this episode, we discuss our present understanding of the COVID19 pandemic. That includes a recap of current events, our knowledge of the virology and pathophysiology of SARS-CoV2, its epidemiology, clinical presentation, diagnostic workup and key findings, current management as well as investigational therapies including ongoing clinical trials.
Thumbnail by T.H. Chia on Unsplash
In this episode, ID doc Lindsay Smith walks us through the importance of antibiotic stewardship and some considerations specific to VT and inpatient vs outpatient practice. We also check out OneHealth, a CDC initiative to study connections between human, animal and environmental health.
Thumbnail by Michael Schiffer on Unsplash
In this episode, we speak with former ACP Governor Dr. Jan Carney about her work as a physician advocate and discuss opportunities for individuals of all levels of medical training to get involved.
For more opportunities, contact Dr. Carney at jan.carney@med.uvm.edu
Thumbnail by Joshua Sukoff on Unsplash
In this episode, we discuss what it means to be an ACP member, involvement opportunities afforded at the local & national levels, and where our VT chapter fits into it all. ACP VT Chapter Governor Allen Repp gives us the inside scoop.
Guest: Dr. Allen Repp, ACP VT Governor